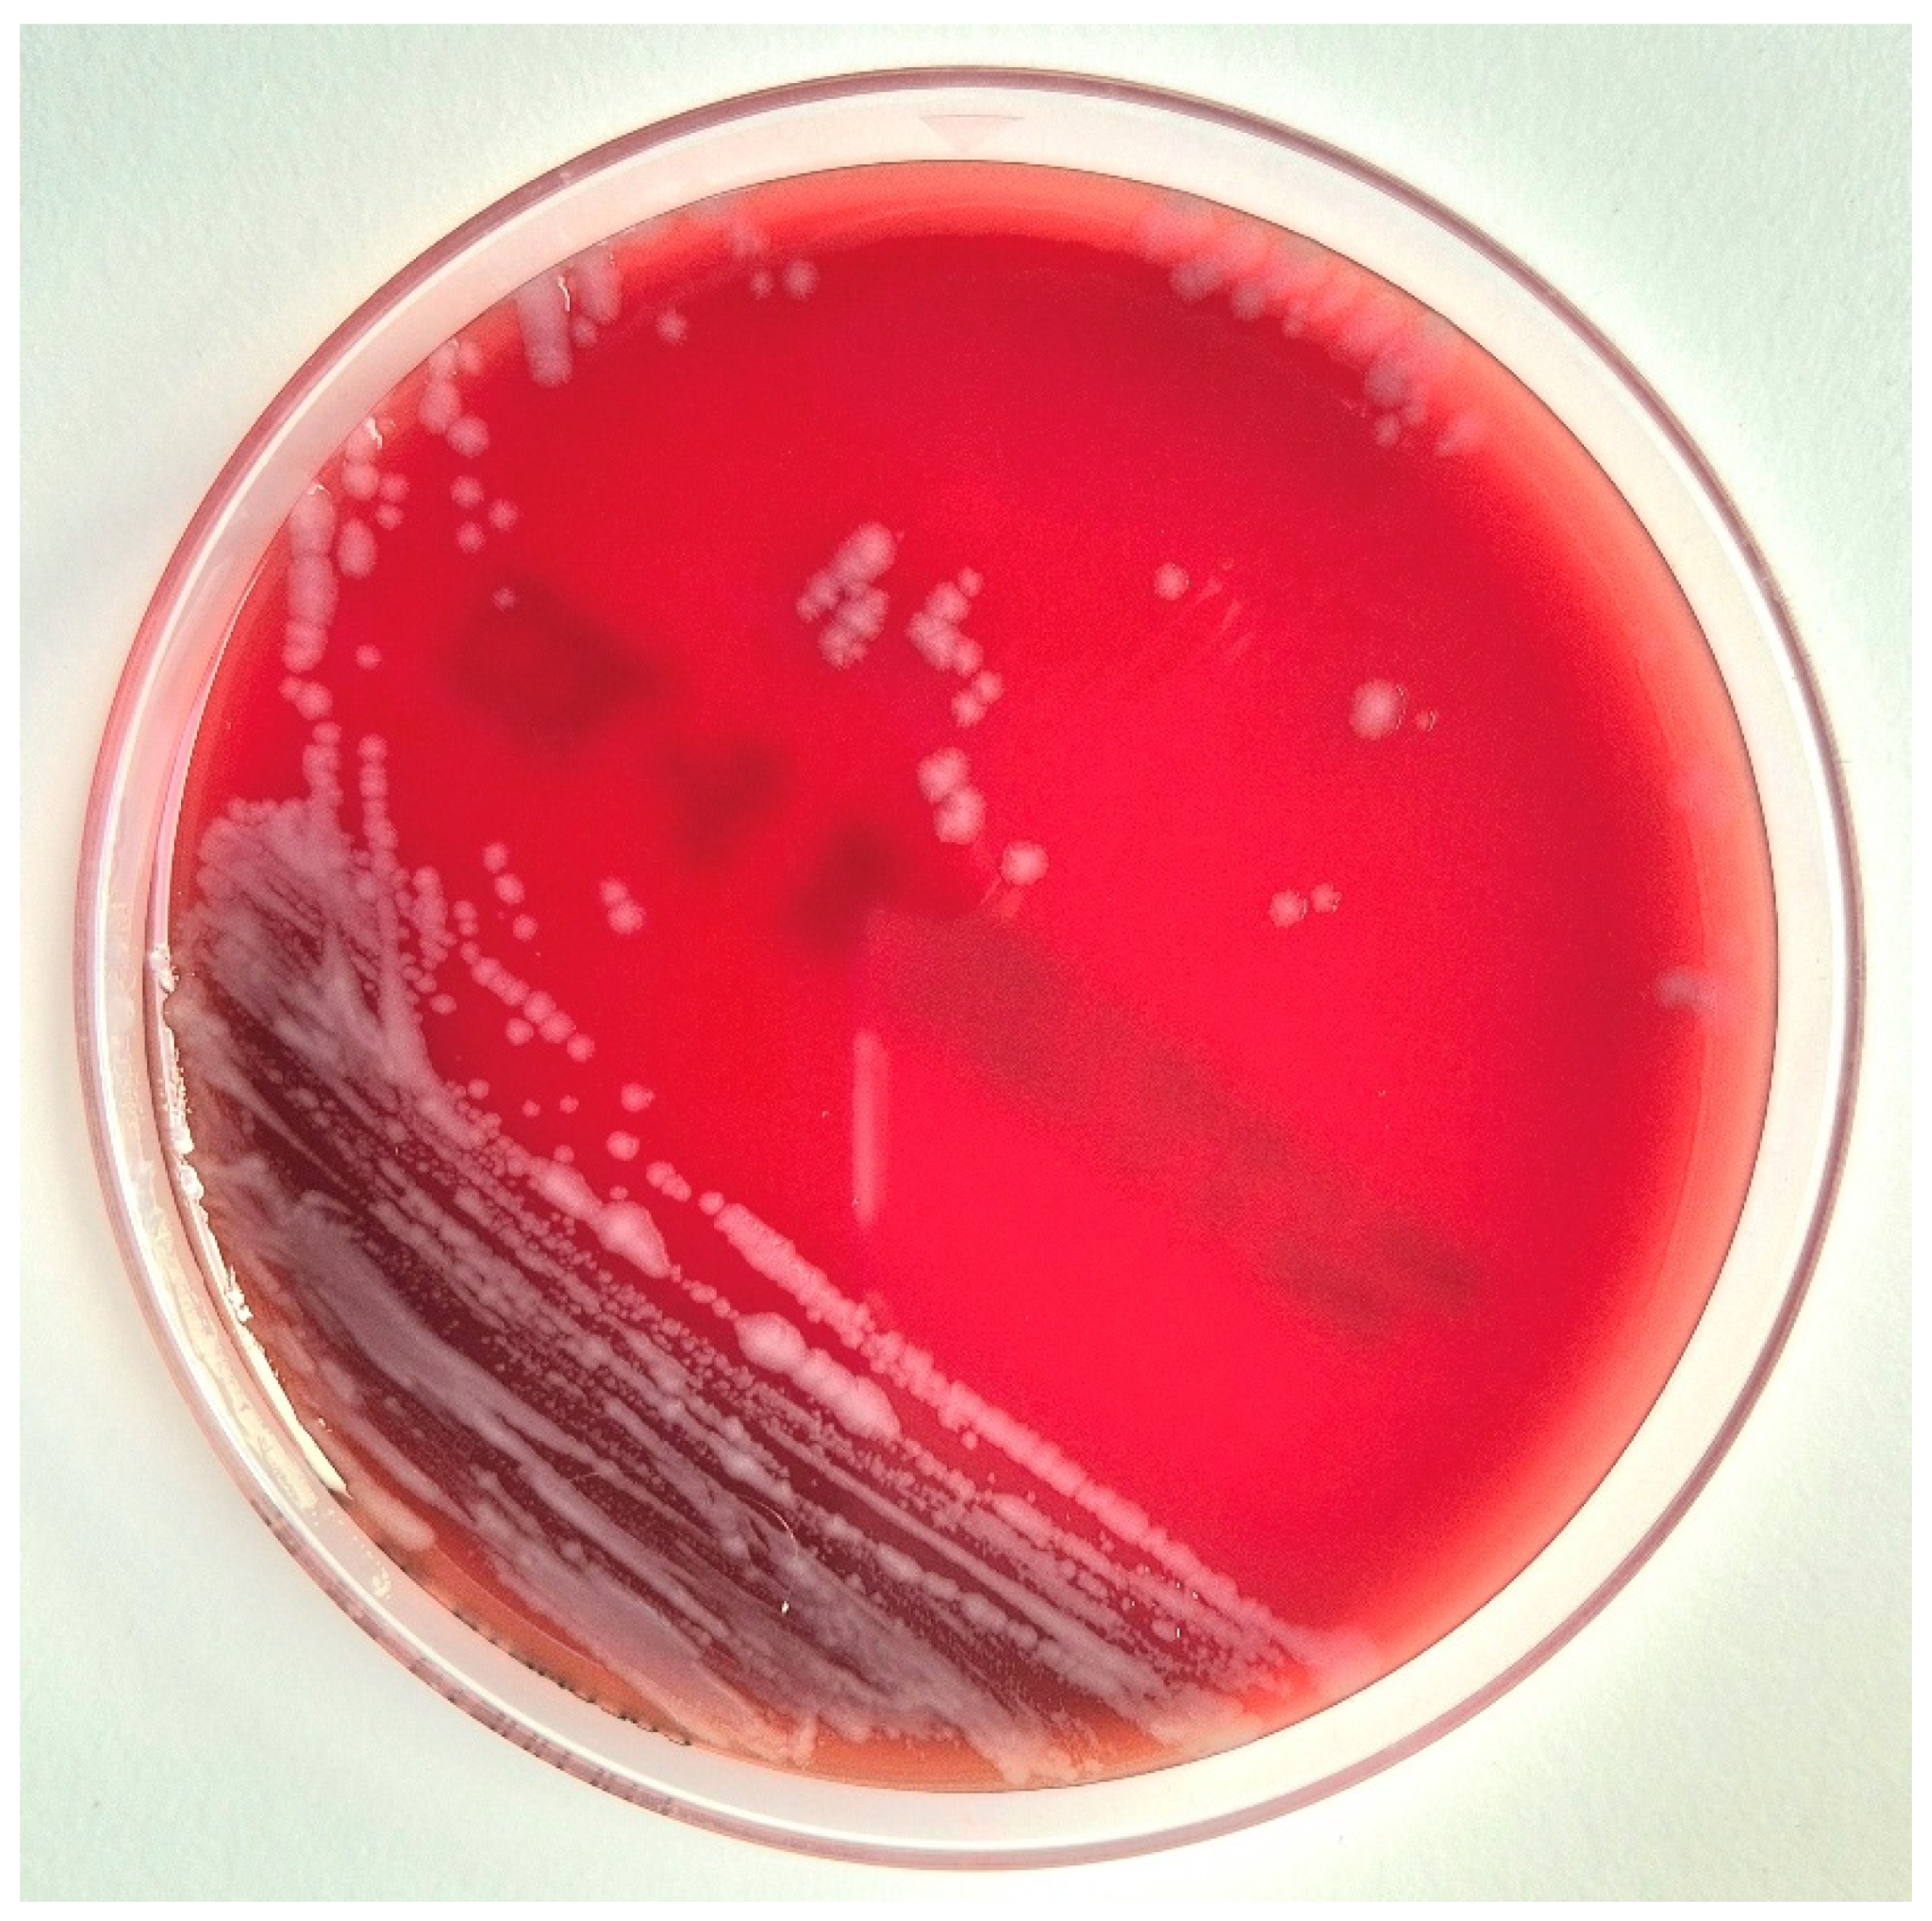
Microorganisms 13 01725 g002

Polymicrobial Arthritis Following a Domestic Cat Bite Involving Rahnella aquatilis in an Immunocompetent Patient
Abstract
1. Introduction
2. Case Presentation
2.1. Clinical Presentation
2.2. Surgical Findings
2.3. Microbiological Analysis
2.4. Treatment and Outcome
3. Discussion
4. Conclusions
Author Contributions
Funding
Institutional Review Board Statement
Informed Consent Statement
Data Availability Statement
Acknowledgments
Conflicts of Interest
References
- Kennedy, S.A.; Stoll, L.E.; Lauder, A.S. Human and other mammalian bite injuries of the hand: Evaluation and management. J. Am. Acad. Orthop. Surg. 2015, 23, 47–57. [Google Scholar] [CrossRef] [PubMed]
- Ellis, R.; Ellis, C. Dog and cat bites. Am. Fam. Physician 2014, 90, 239–243. [Google Scholar] [PubMed]
- Talan, D.A.; Citron, D.M.; Abrahamian, F.M.; Moran, G.J.; Goldstein, E.J.; Emergency Medicine Animal Bite Infection Study Group. Bacteriologic analysis of infected dog and cat bites. N. Engl. J. Med. 1999, 340, 85–92. [Google Scholar] [CrossRef] [PubMed]
- Butt, T.S.; Khan, A.; Ahmad, A.; Khan, M.A.; Parke, A.; Hill, D.R. Pasteurella multocida infectious arthritis with acute gout after a cat bite. J. Rheumatol. 1997, 24, 1649–1652. [Google Scholar] [PubMed]
- Alifragki, A.; Kontogianni, A.; Protopapa, I.; Baliou, S.; Ioannou, P. Infective endocarditis by Pasteurella species: A systematic review. J. Clin. Med. 2022, 11, 5037. [Google Scholar] [CrossRef]
- Vecilla, D.F.; Matheus, M.P.R.; Hidalgo, G.I.; de Tuesta Del Arco, J.L.D. Osteomyelitis caused by Pasteurella multocida and Bacteroides pyogenes after cat bite. Eur. J. Clin. Microbiol. Infect. Dis. 2023, 42, 125–128. [Google Scholar] [CrossRef] [PubMed]
- Sadhwani, S.; DiAngelis, D.; Brown, M.; Ferguson, C.; Angerett, N. Unique presentation of an intramuscular abscess caused by Bacteroides pyogenes in the setting of a cat bite: A case report. SAGE Open Med. Case Rep. 2024, 12, 2050313X231222217. [Google Scholar] [CrossRef] [PubMed]
- Madsen, I.R.; Justesen, U.S. Bacteremia with Bacteroides pyogenes after a cat bite. J. Clin. Microbiol. 2011, 49, 3092–3093. [Google Scholar] [CrossRef] [PubMed][Green Version]
- Shukla, S.K.; Paustian, D.L.; Stockwell, P.J.; Morey, R.E.; Jordan, J.G.; Levett, P.N.; Frank, D.N.; Reed, K.D. Isolation of a fastidious Bergeyella species associated with cellulitis after a cat bite and a phylogenetic comparison with Bergeyella zoohelcum strains. J. Clin. Microbiol. 2004, 42, 290–293. [Google Scholar] [CrossRef] [PubMed][Green Version]
- Kaiser, R.M.; Garman, R.L.; Bruce, M.G.; Weyant, R.S.; Ashford, D.A. Clinical significance and epidemiology of NO-1, an unusual bacterium associated with dog and cat bites. Emerg. Infect. Dis. 2002, 8, 171–174. [Google Scholar] [CrossRef] [PubMed]
- Dolieslager, S.M.J.; Bennett, D.; Johnston, N.; Riggio, M.P. Novel bacterial phylotypes associated with the healthy feline oral cavity and feline chronic gingivostomatitis. Res. Vet. Sci. 2013, 94, 428–432. [Google Scholar] [CrossRef] [PubMed]
- Gavini, F.; Ferragut, C.; Lefebvre, B.; Leclerc, H. Étude taxonomique d’entérobactéries appartenant ou apparentées au genre Enterobacter. Ann. Microbiol. (Inst. Pasteur.) 1976, 127B, 317–335. [Google Scholar]
- Sturgeon, A.; Pinder, S.L.; Costa, M.C.; Weese, J.S. Characterization of the oral microbiota of healthy cats using next-generation sequencing. Vet. J. 2014, 202, 463–467. [Google Scholar] [CrossRef] [PubMed]
- Carinder, J.E.; Chua, J.D.; Corales, R.B.; Taege, A.J.; Procop, G.W. Rahnella aquatilis bacteremia in a patient with relapsed acute lymphoblastic leukemia. Scand. J. Infect. Dis. 2001, 33, 471–473. [Google Scholar] [CrossRef]
- Funke, G.; Rosner, H. Rahnella aquatilis bacteremia in an HIV-infected intravenous drug abuser. Diagn. Microbiol. Infect. Dis. 1995, 22, 293–296. [Google Scholar] [CrossRef] [PubMed]
- Oh, H.M.; Tay, L. Bacteraemia caused by Rahnella aquatilis: Report of two cases and review. Scand. J. Infect. Dis. 1995, 27, 79–80. [Google Scholar] [CrossRef] [PubMed]
- Roeder, H.A.; Fuller, B.; Scoular, S. Septic shock caused by Rahnella aquatilis bacteremia in an immunocompetent adult. Am. J. Case Rep. 2021, 22, e930888-1–e930888-4. [Google Scholar] [CrossRef] [PubMed] [PubMed Central]
- Chang, C.L.; Jeong, J.; Shin, J.H.; Lee, E.Y.; Son, H.C. Rahnella aquatilis sepsis in an immunocompetent adult. J. Clin. Microbiol. 1999, 37, 4161–4162. [Google Scholar] [CrossRef] [PubMed] [PubMed Central]
- Martins, W.; Carvalhaes, C.G.; Cayô, R.; Gales, A.C.; Pignatari, A.C. Co-transmission of Rahnella aquatilis between hospitalized patients. Braz. J. Infect. Dis. 2015, 19, 648–650. [Google Scholar] [CrossRef]
- Liang, J.; Hu, X.; Lü, A.; Sun, J. First report on the characterization of pathogenic Rahnella aquatilis KCL-5 from crucian carp: Revealed by genomic and proteomic analyses. J. Fish Dis. 2020, 43, 889–914. [Google Scholar] [CrossRef]
- Kennedy, C.D.; Huang, J.I.; Hanel, D.P. In Brief: Kanavel’s Signs and Pyogenic Flexor Tenosynovitis. Clin. Orthop. Relat. Res. 2016, 474, 280–284. [Google Scholar] [CrossRef]
- Medeiros, I.; Saconato, H. Antibiotic prophylaxis for mammalian bites. Cochrane Database Syst. Rev. 2001, CD001738. [Google Scholar] [CrossRef] [PubMed]
- Mitnovetski, S.; Kimble, F. Cat bites of the hand. ANZ J. Surg. 2004, 74, 859–862. [Google Scholar] [CrossRef]
- Kheiran, A.; Palial, V.; Rollett, R.; Wildin, C.J.; Chatterji, U.; Singh, H.P. Cat bite: An injury not to underestimate. J. Plast. Surg. Hand Surg. 2019, 53, 341–346. [Google Scholar] [CrossRef] [PubMed]
- Dewhirst, F.E.; Chen, T.; Izard, J.; Paster, B.J.; Tanner, A.C.; Yu, W.H.; Lakshmanan, A.; Wade, W.G. The human oral microbiome. J. Bacteriol. 2010, 192, 5002–5017. [Google Scholar] [CrossRef]

Disclaimer/Publisher’s Note: The statements, opinions and data contained in all publications are solely those of the individual author(s) and contributor(s) and not of MDPI and/or the editor(s). MDPI and/or the editor(s) disclaim responsibility for any injury to people or property resulting from any ideas, methods, instructions or products referred to in the content. |
© 2025 by the authors. Licensee MDPI, Basel, Switzerland. This article is an open access article distributed under the terms and conditions of the Creative Commons Attribution (CC BY) license (https://creativecommons.org/licenses/by/4.0/).
Share and Cite
Nicod, O.; Tré-Hardy, M.; Baillon, B.; Beukinga, I.; Ngatchou, W.; Riahi, N.; Blairon, L. Polymicrobial Arthritis Following a Domestic Cat Bite Involving Rahnella aquatilis in an Immunocompetent Patient. Microorganisms 2025, 13, 1725. https://doi.org/10.3390/microorganisms13081725
Nicod O, Tré-Hardy M, Baillon B, Beukinga I, Ngatchou W, Riahi N, Blairon L. Polymicrobial Arthritis Following a Domestic Cat Bite Involving Rahnella aquatilis in an Immunocompetent Patient. Microorganisms. 2025; 13(8):1725. https://doi.org/10.3390/microorganisms13081725
Chicago/Turabian StyleNicod, Olivier, Marie Tré-Hardy, Bruno Baillon, Ingrid Beukinga, William Ngatchou, Nada Riahi, and Laurent Blairon. 2025. "Polymicrobial Arthritis Following a Domestic Cat Bite Involving Rahnella aquatilis in an Immunocompetent Patient" Microorganisms 13, no. 8: 1725. https://doi.org/10.3390/microorganisms13081725
APA StyleNicod, O., Tré-Hardy, M., Baillon, B., Beukinga, I., Ngatchou, W., Riahi, N., & Blairon, L. (2025). Polymicrobial Arthritis Following a Domestic Cat Bite Involving Rahnella aquatilis in an Immunocompetent Patient. Microorganisms, 13(8), 1725. https://doi.org/10.3390/microorganisms13081725

